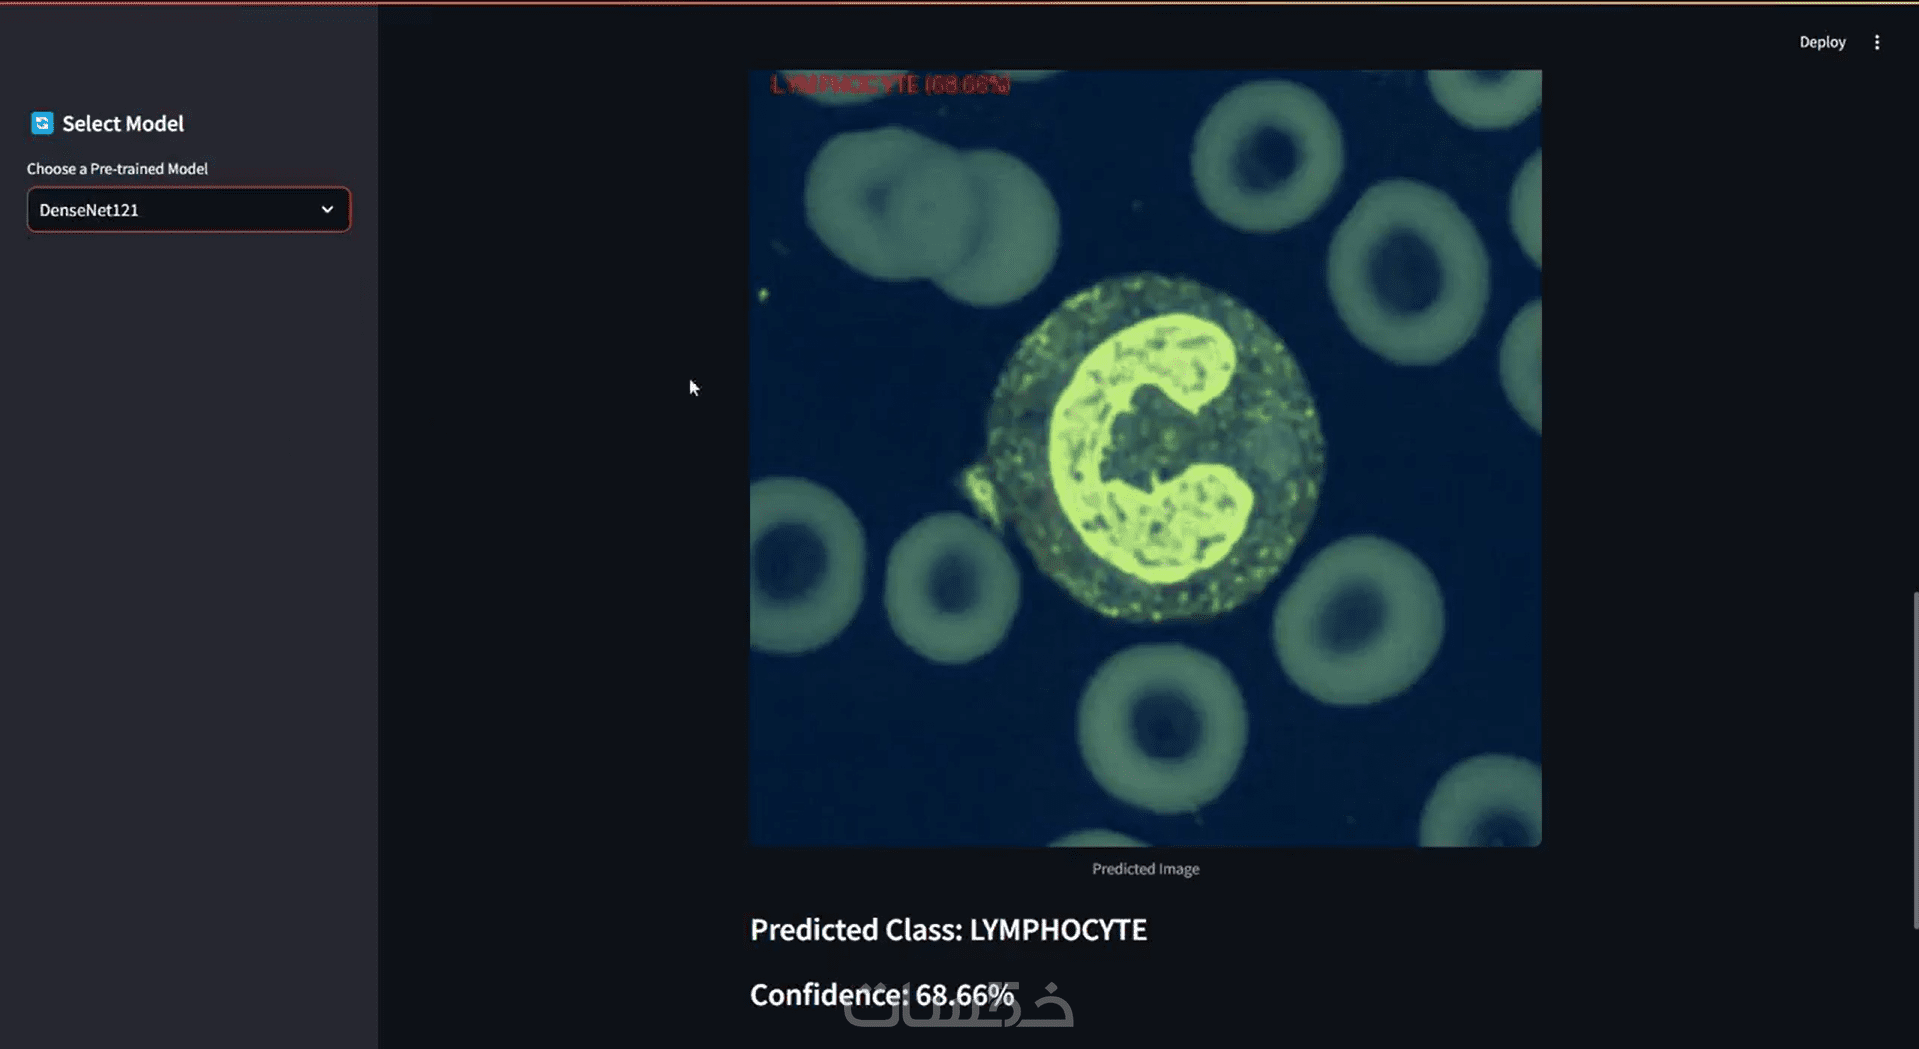

بناء نماذج ذكاء اصطناعي وتعلم آلة
بناء نماذج ذكاء اصطناعي وتعلم آلة
وصف الخدمة
هل لديك بيانات، صور، أو فكرة مشروع ذكاء اصطناعي وتريد تحويلها إلى نموذج عملي ودقيق؟
أنا مهندس ذكاء اصطناعي وتعلم آلة أمتلك خبرة عملية في بناء حلول Machine Learning، Deep Learning، Computer Vision، وتحليل البيانات من مرحلة فهم المشكلة وتحضير البيانات وحتى تدريب النموذج، تقييمه، وعرضه داخل واجهة تفاعلية إذا لزم الأمر.
أساعدك في تنفيذ مشاريع احترافية مثل:
Classification تصنيف البيانات أو الصور
Regression التنبؤ بالأسعار أو القيم المستقبلية
Clustering تقسيم البيانات واكتشاف الأنماط
Computer Vision مثل تصنيف الصور، المعالجة، واكتشاف العناصر
تحليل البيانات واستخراج Insights
بناء واجهات تفاعلية للمشروع باستخدام Streamlit أو PyQt5
ما الذي سأقدمه لك في هذه الخدمة
فهم الفكرة أو المشكلة وتحديد أنسب حل تقني
تنظيف وتجهيز البيانات أو الصور قبل التدريب
تنفيذ EDA وتحليل استكشافي للبيانات
بناء pipeline واضحة لمعالجة البيانات
اختيار الخوارزمية أو المعمارية المناسبة للمشروع
تدريب النموذج وتحسين الأداء
تقييم النموذج باستخدام المقاييس المناسبة مثل:
Accuracy
Precision / Recall / F1-Score
Confusion Matrix
MAE / MSE / RMSE / R²
شرح النتائج بشكل مبسط وواضح
تسليم الكود بشكل منظم وقابل للتطوير
إمكانية دمج النموذج داخل واجهة بسيطة للتجربة والتشغيل
مميزات الخدمة
مميزات الخدمة
خبرة عملية في مشاريع حقيقية من البداية للنهاية
القدرة على بناء نماذج تعلم آلة ورؤية حاسوبية مع واجهات تشغيل تفاعلية
كود نظيف ومنظم وسهل الفهم والتطوير
تحليل دقيق للبيانات قبل بناء النموذج
تحسين أداء النموذج باستخدام أساليب التقييم والـ tuning
دعم فني بعد التسليم للرد على الاستفسارات
إمكانية تسليم المشروع كنوتبوك، سكريبت، أو نموذج محفوظ جاهز للاستخدام
الخدمة مناسبة لمشاريع
التنبؤ بالأسعار أو المبيعات
تصنيف العملاء أو المنتجات
تحليل بيانات المشاريع والأبحاث
بناء نماذج تصنيف صور
مشاريع المعالجة الرقمية للصور
تطوير نموذج ذكاء اصطناعي مع واجهة Streamlit أو PyQt5
ما الذي ستستلمه؟
ملف Jupyter Notebook أو Python Script
النموذج المدرب بصيغة مناسبة مثل:
.pkl
.h5
.ipynb
.py
تقرير مبسط يوضح النتائج والأداء
رسوم بيانية وتحليل للبيانات عند الحاجة
واجهة تشغيل بسيطة للمشروع إذا كانت ضمن الاتفاق
كلمات مفتاحية
خدمات قد تنال إعجابك
آراء المشترين
رجل مبدع متعاون وخلوق في مجال تعلم الاله machine learning .. ومجتهد في تطوير العمل واخراجه حتى بعد استلام الطلب … بالاضافه الى سعر الخدمه المعقول انصح بالتعامل معه شكرا مهندس مارك
شكرًا جزيلًا أستاذ شاكر على كلامك الطيب وتقييمك الكريم، سعدت جدًا بالتعامل مع حضرتك يشرفني أن العمل نال رضاكم، وأنا دائمًا موجود لأي تعديلات أو تطوير إضافي بعد التسليم تشرفت بالتعامل معك، وأتمنى أن يجمعنا تعاون جديد قريبًا بإذن الله
يعطيك العافيه مارك جوده في الخدمة و التسليم على الوقت وسرعه التواصل و المتابعه
بطاقة الخدمة
شراء الخدمة
سعر الخدمة
$15.00
خدمات قد تنال إعجابك
آراء المشترين
رجل مبدع متعاون وخلوق في مجال تعلم الاله machine learning .. ومجتهد في تطوير العمل واخراجه حتى بعد استلام الطلب … بالاضافه الى سعر الخدمه المعقول انصح بالتعامل معه شكرا مهندس مارك
شكرًا جزيلًا أستاذ شاكر على كلامك الطيب وتقييمك الكريم، سعدت جدًا بالتعامل مع حضرتك يشرفني أن العمل نال رضاكم، وأنا دائمًا موجود لأي تعديلات أو تطوير إضافي بعد التسليم تشرفت بالتعامل معك، وأتمنى أن يجمعنا تعاون جديد قريبًا بإذن الله
يعطيك العافيه مارك جوده في الخدمة و التسليم على الوقت وسرعه التواصل و المتابعه